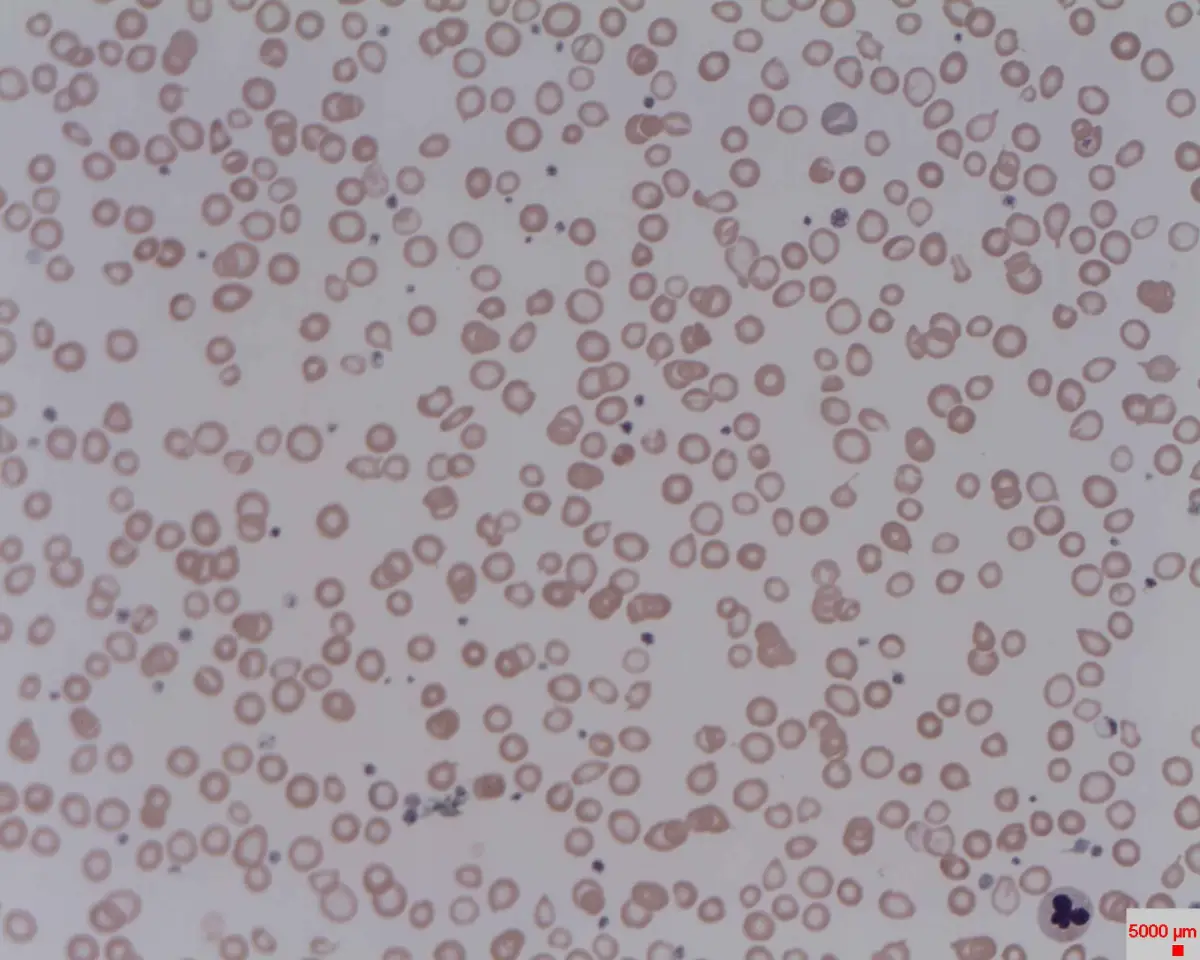
Anemia: Sintomas, Causas e Tratamentos Eficazes

Calculadora de Água Diária — Quantos Litros Devo Beber?
Calcula quantos litros de água deves beber por dia com base no teu peso, nível de actividade e estação do ano — com dicas práticas adaptadas ao dia a dia português.

Calcula quantos litros de água deves beber por dia com base no teu peso, nível de actividade e estação do ano — com dicas práticas adaptadas ao dia a dia português.

Calcula o teu Índice de Massa Corporal (IMC) e percebe o que o resultado significa — com explicação clara das categorias da OMS e da DGS.

A inflamação crónica está na origem de muitas doenças modernas. Conheça os alimentos anti-inflamatórios mais eficazes, o que deve evitar e como adaptar a sua dieta ao dia a dia português.

O Ozempic (semaglutida) é um injetável semanal aprovado para a diabetes tipo 2 que também promove a perda de peso. Saiba como funciona, quais os efeitos secundários reais e quando deve consultar o médico.

O Foundayo (orforglipron) representa uma revolução no tratamento da obesidade: é o primeiro agonista do recetor GLP-1 disponível em comprimido. Saiba como atua, para quem está indicado e o que mostram os estudos mais recentes.

Os chás detox estão na moda, mas será que funcionam? Este artigo explica os benefícios reais versus os mitos, os riscos para grupos vulneráveis e as alternativas seguras para desintoxicação natural.

A síndrome do intestino irritável afeta milhões de portugueses e causa dor abdominal, distensão e alterações no trânsito intestinal. Saiba como identificar os sintomas e encontrar alívio.

A gastroenterite é uma das infeções gastrointestinais mais comuns, especialmente na primavera. Saiba como reconhecê-la, preveni-la e recuperar corretamente.

O défice de ferro é uma das carências nutricionais mais comuns em Portugal, especialmente entre mulheres adultas. Saiba reconhecer os sinais, entender as causas e agir com eficácia.
A anemia é uma das condições de saúde mais prevalentes a nível mundial. Descubra os principais tipos, sintomas de alerta, formas de diagnóstico e tratamentos eficazes para recuperar a sua qualidade de vida.

Escolher o melhor drenante pode fazer toda a diferença no seu bem-estar. Neste guia, explicamos o que são os drenantes, como funcionam e qual o mais indicado para si.

A Saxenda é um medicamento prescrito para ajudar a perder peso em adultos com excesso de peso ou obesidade. Saiba como funciona, como se usa e quais os cuidados a ter.